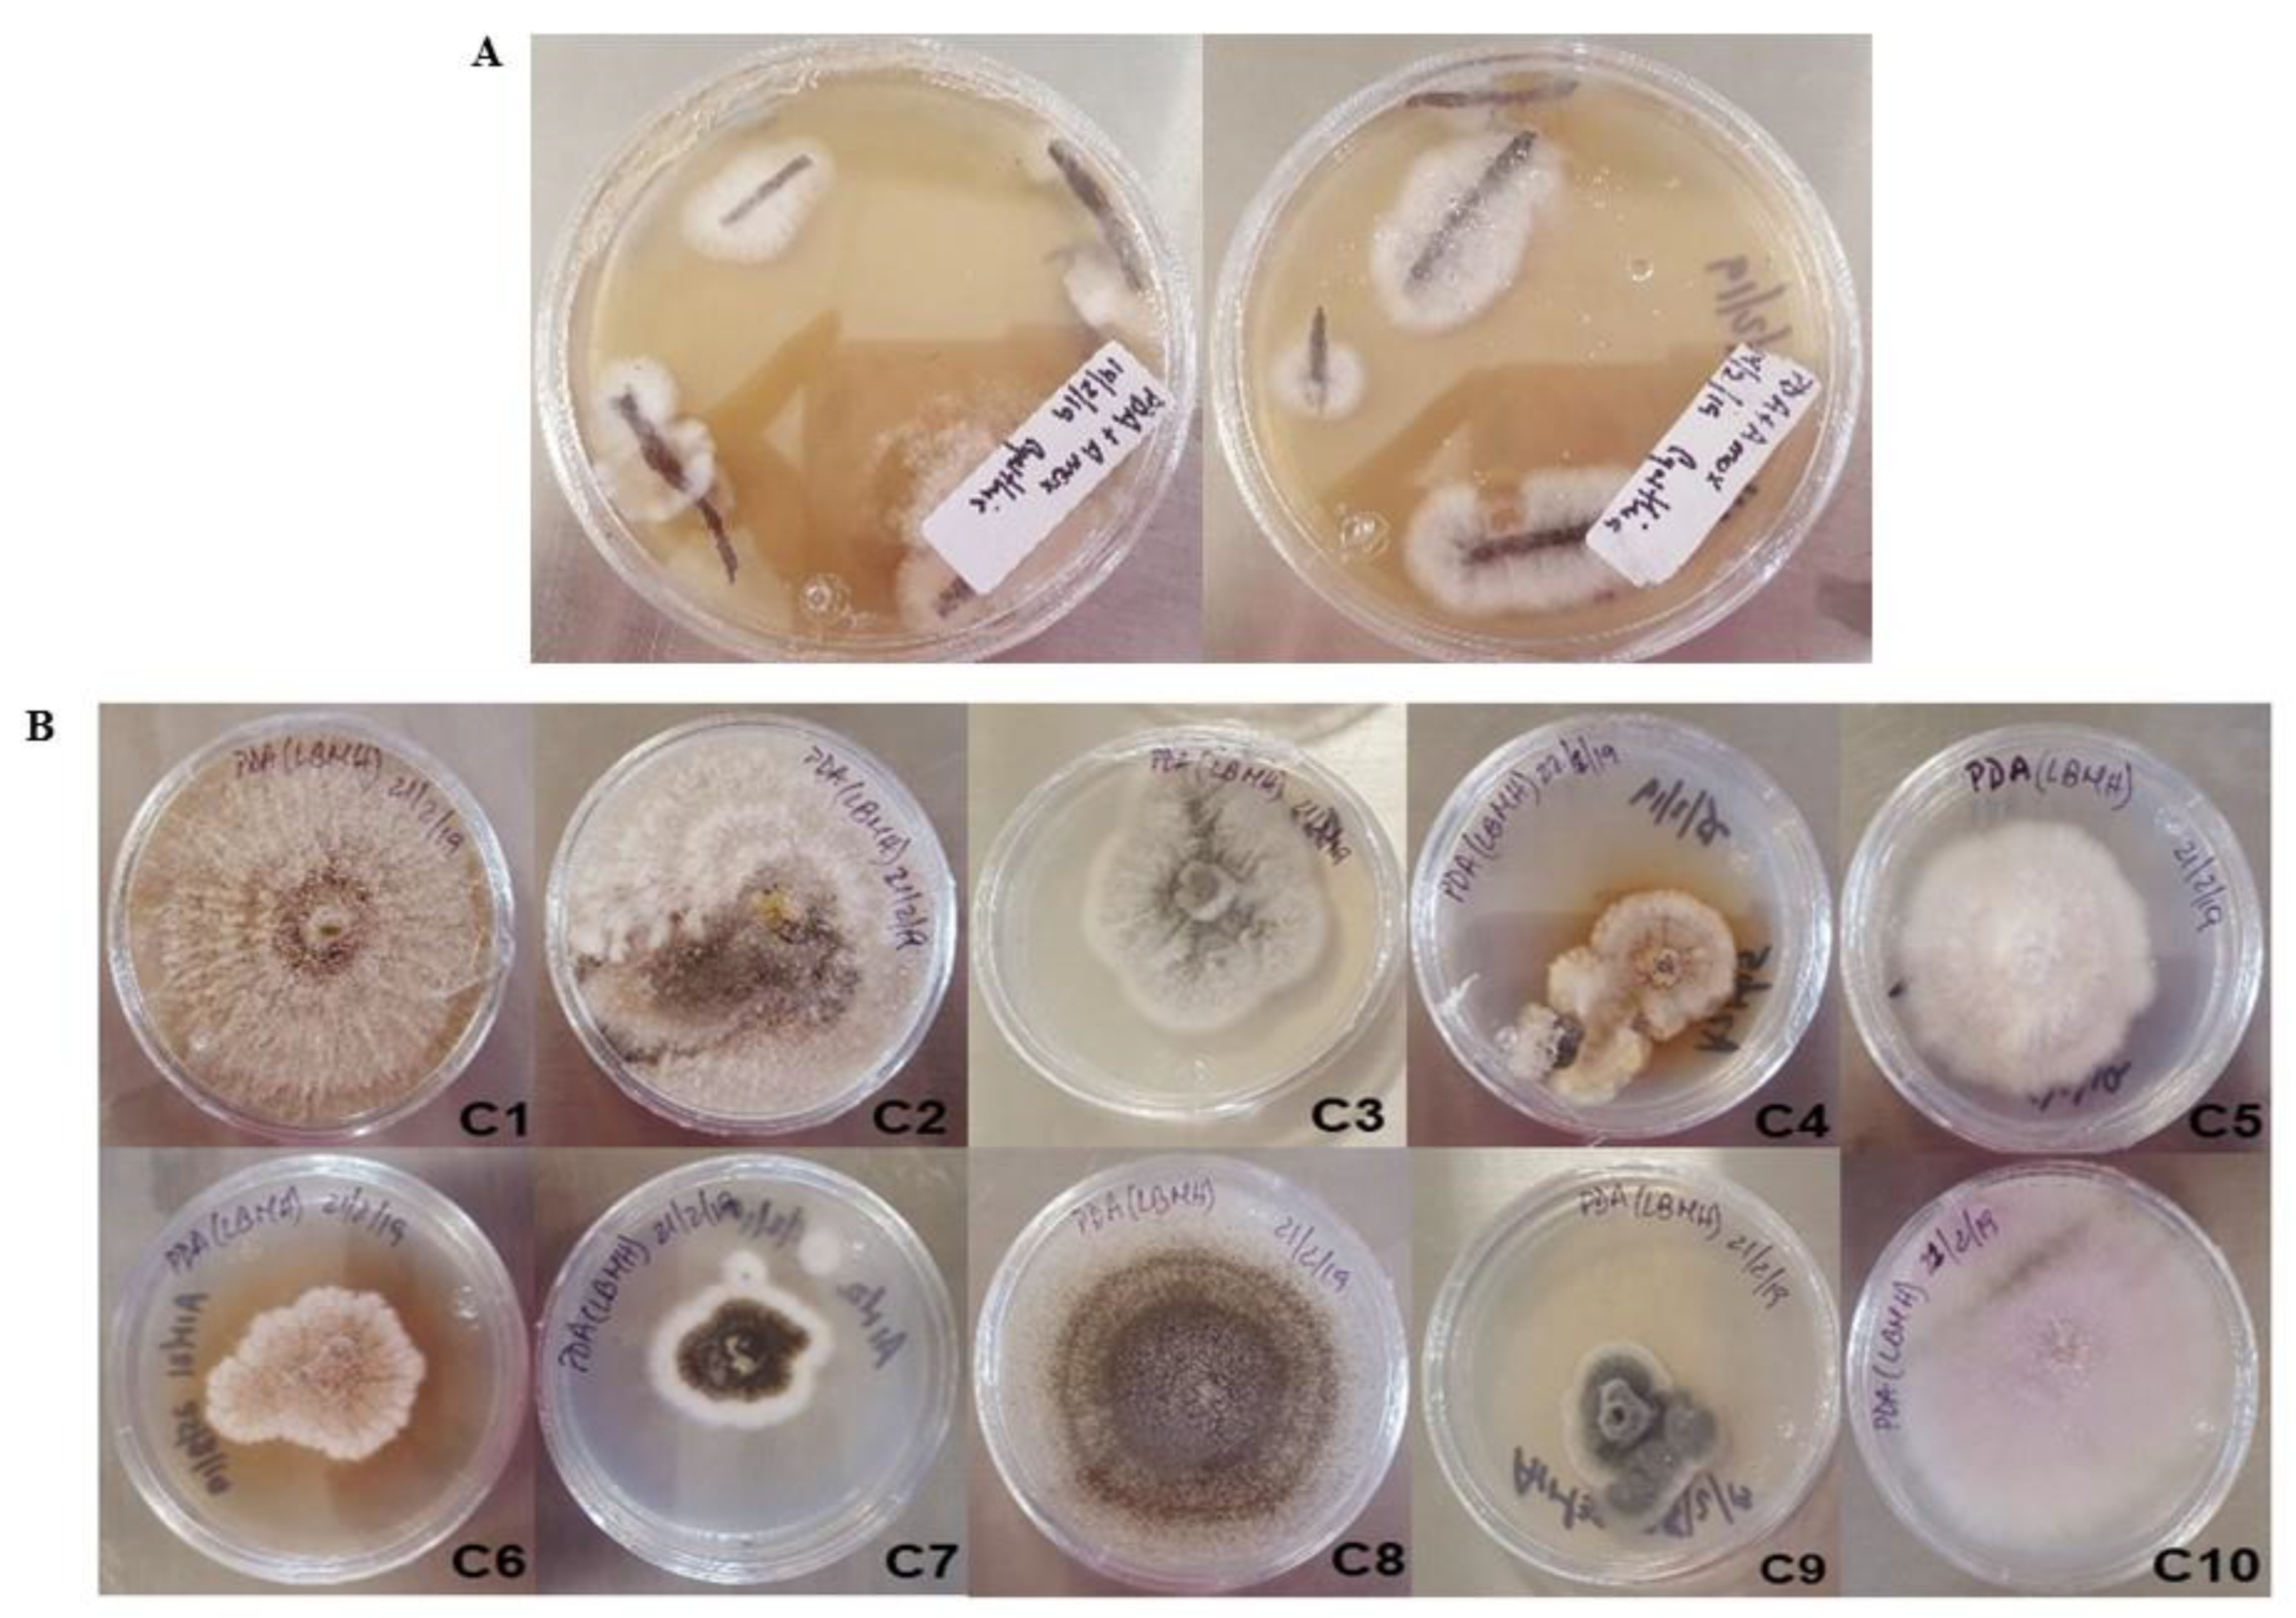

Aspergillus luchuensis, an Endophyte Fungus from the Metal Hyperaccumulator Plant Prosopis laevigata, Promotes Its Growth and Increases Metal Translocation
Abstract
1. Introduction
2. Results
2.1. Isolation and Screening of Endophytic Fungi from P. laevigata
2.2. Preliminary Screening for Metal Tolerance of the Isolates from P. laevigata Roots
2.3. Characterization of Growth Rate and MIC for Selected Isolates from P. laevigata Roots
2.4. Identification and Molecular Analysis of Strain C7
2.5. Plant Growth Promotion of A. luchuensis C7 on P. laevigata in Substrates with or without Metals
2.6. Influence of Heavy Metal Exposure on Size Characters in P. laevigata Individuals
2.7. Effect of Treatments on Size Characters in P. laevigata Individuals
2.8. Relationship between Exposure Time and Size Characters in P. laevigata Individuals
2.9. Heavy Metal Bioaccumulation in P. laevigata Individuals along Exposure Times
2.10. Translocation Coefficient in P. laevigata Individuals
3. Discussion
3.1. Molecular Analysis and Metal Tolerance of the Isolates from P. laevigata Roots
3.2. Plant Growth Promotion of A. luchuensis C7 and Influence of Heavy Metal Exposure on Size Characters in P. laevigata Individuals
3.3. Heavy Metal Bioaccumulation and Translocation in P. laevigata Individuals
4. Materials and Methods
4.1. Plant Species
4.2. P. laevigata Sampling and Root Collection
4.3. Fungal Endophyte Isolation
4.4. Minimum Inhibitory Concentration (MIC) as Inhibition of Radial Growth of the Fungal Isolates
4.5. Growth Rate and Inhibition Percentage of Endophytic Fungal Strains
4.6. Identification of Endophytic Fungal Strain C7
4.7. Seed Collection and Germination of P. laevigata for Plant Growth Promotion and Metal Accumulation Experiments
4.8. Tailing and Reference Substrates Sampling for Plant Growth Experiments
4.9. Growing of P. laevigata in Control and Tailing Substrates with or without Fungal Inoculation
4.10. Inoculum Preparation for P. laevigata
4.11. Plant Growth Promotion
4.12. Concentration of Heavy Metals in Roots and Leaves of P. laevigata during Growth in the Presence or Absence of A. luchuensis C7, in Tailing and Control Substrates
4.13. Statistical Analysis
5. Conclusions
Supplementary Materials
Author Contributions
Funding
Data Availability Statement
Acknowledgments
Conflicts of Interest
References
- Vardhan, K.H.; Kumar, P.S.; Panda, R.C. A Review on heavy metal pollution, Toxicity and remedial measures: Current trends and future perspectives. J. Mol. Liq. 2019, 290, 111197. [Google Scholar] [CrossRef]
- Zhang, G.; Morais, M.C.; Dai, J.; Zhang, W.; Dunaway-Mariano, D.; Allen, K.N. Investigation of metal ion binding in phosphonoacetaldehyde hydrolase identifies sequence markers for metal-activated enzymes of the HAD enzyme superfamily. Biochemistry 2004, 43, 4990–4997. [Google Scholar] [CrossRef] [PubMed]
- Hernick, M.; Fierke, C.A. Zinc hydrolases: The mechanisms of zinc-dependent deacetylases. Arch. Biochem. Biophys. 2005, 433, 71–84. [Google Scholar] [CrossRef] [PubMed]
- Einsle, O.; Rees, D.C. Structural enzymology of nitrogenase enzymes. Chem. Rev. 2020, 120, 4969–5004. [Google Scholar] [CrossRef] [PubMed]
- Johnson, M.K.; Scott, R. Metalloprotein Active Site Assembly; EIC Books; Wiley: Chichester, UK, 2017. [Google Scholar]
- Gasic, K.; Korban, S.S. Heavy metal stress. In Physiology and Molecular Biology of Stress Tolerance in Plants; Madhava, R.K.V., Raghavendra, A.S., Janardhan, R.K., Eds.; Kluwer Academic Publishers: Dordrecht, The Netherlands, 2006; pp. 219–254. [Google Scholar] [CrossRef]
- Kumar, Y.K.; Gupta, N.; Kumar, A.; Reece, L.M.; Singh, N.; Rezania, S.; Ahmad, K.S. Mechanistic understanding and holistic approach of phytoremediation: A review on application and future prospects. Ecol. Eng. 2018, 120, 274–298. [Google Scholar] [CrossRef]
- Muthusaravanan, S.; Sivarajasekar, N.; Vivek, J.S.; Paramasivan, T.; Naushad, M.; Prakashmaran, J.; Gayathri, V.; Al-Duaij, O.K. Phytoremediation of heavy metals: Mechanisms, methods, and enhancements. Environ. Chem. Lett. 2018, 16, 1339–1359. [Google Scholar] [CrossRef]
- Ashraf, S.; Ali, Q.; Zahir, Z.A.; Ashraf, S.; Asghar, H.N. Phytoremediation: Environmentally sustainable way for reclamation of heavy metal polluted soils. Ecotoxicol. Environ. Saf. 2019, 174, 714–727. [Google Scholar] [CrossRef]
- Shah, V.; Daverey, A. Phytoremediation: A multidisciplinary approach to clean up heavy metal contaminated soil. Environ. Technol. Innov. 2020, 18, 100774. [Google Scholar] [CrossRef]
- Verma, S.; Kuila, A. Bioremediation of heavy metals by microbial process. Environ. Technol. Innov. 2019, 14, 100369. [Google Scholar] [CrossRef]
- Khan, A.G. Mycorrhizoremediation-An enhanced form of phytoremediation. J. Zhejiang Univ. Sci. B 2006, 7, 503–514. [Google Scholar] [CrossRef]
- Cecchi, G.; Vagge, G.; Cutroneo, L.; Greco, G.; Di Piazza, S.; Faga, M.; Zotti, M.; Capello, M. Fungi as potential tool for polluted port sediment remediation. Environ. Sci. Pollut. Res. 2019, 26, 35602–35609. [Google Scholar] [CrossRef] [PubMed]
- Salazar-Ramírez, G.; Flores-Vallejo, R.; Rivera-Leyva, J.C.; Tovar-Sánchez, E.; Sánchez-Reyes, A.; Mena-Portales, J.; Sánchez-Carbente, M.R.; Gaitán-Rodríguez, M.F.; Batista-García, R.A.; Villarreal, M.L.; et al. Characterization of fungal endophytes isolated from the metal hyperaccumulator plant Vachellia farnesiana growing in mine tailings. Microorganisms 2020, 8, 226. [Google Scholar] [CrossRef] [PubMed]
- Otero-Blanca, A.; Folch-Mallol, J.L.; Lira-Ruan, V.; Sánchez, C.M.R.; Batista-García, R.A. Phytoremediation and fungi: An underexplored binomial. In Approaches in Bioremediation, Nanotechnology in the Life Sciences; Prasad, R., Aranda, E., Eds.; Springer International Publishing: Cham, Switzerland, 2018; pp. 79–95. [Google Scholar] [CrossRef]
- Kumar, A.; Singh, A.K.; Choudhary, K.K. Role of Plant Growth Promoting Microorganisms in Sustainable Agriculture and Nanotechnology; Woodhead Publishing: Duxford, UK; Cambridge, MA, USA, 2019. [Google Scholar]
- Beauvais, A.; Latgé, J.P. Special Issue: Fungal cell wall. J. Fungi 2018, 4, 91. [Google Scholar] [CrossRef]
- Hyde, K.D.; Xu, J.; Rapior, S.; Jeewon, R.; Lumyong, S.; Niego, A.G.T.; Abeywickrama, P.D.; Aluthmuhandiram, J.V.S.; Brahamanage, R.S.; Brooks, S.; et al. The amazing potential of fungi: 50 ways we can exploit fungi industrially. Fungal Divers. 2019, 97, 1–136. [Google Scholar] [CrossRef]
- Khullar, S.; Reddy, M.S. Ectomycorrhizal fungi and its role in metal homeostasis through metallothionein and glutathione mechanisms. Curr. Biotechnol. 2018, 7, 231–241. [Google Scholar] [CrossRef]
- Samuel, M.S.; Datta, S.; Khandge, R.S.; Selvarajan, E. A state of the art review on characterization of heavy metal binding metallothioneins proteins and their widespread applications. Sci. Total Environ. 2021, 775, 145829. [Google Scholar] [CrossRef]
- Su, R.; Ou, Q.; Wang, H.; Luo, Y.; Dai, X.; Wang, Y.; Chen, Y.; Shi, L. Comparison of phytoremediation potential of nerium indicum with inorganic modifier calcium carbonate and organic modifier mushroom residue to lead–zinc tailings. Int. J. Environ. Res. Public Health 2022, 19, 10353. [Google Scholar] [CrossRef]
- Miransari, M. Arbuscular mycorrhizal fungi and heavy metal tolerance in plants. In Arbuscular Mycorrhizas and Stress Tolerance of Plants; Wu, Q.S., Ed.; Springer: Singapore, 2017; pp. 147–161. [Google Scholar] [CrossRef]
- Maldaner, J.; Steffen, G.P.K.; Missio, E.L.; Saldanha, C.W.; de Morais, R.M.; Nicoloso, F.T. Tolerance of Trichoderma isolates to increasing concentrations of heavy metals. Int. J. Environ. Stud. 2021, 78, 185–197. [Google Scholar] [CrossRef]
- Khalid, M.; Ur-Rahman, S.; Hassani, D.; Hayat, K.; Zhou, P.; Hui, N. Advances in fungal-assisted phytoremediation of heavy metals: A review. Pedosphere 2021, 31, 475–495. [Google Scholar] [CrossRef]
- Bilal, S.; Shahzad, R.; Imran, M.; Jan, R.; Kim, K.M.; Lee, I.J. Synergistic association of endophytic fungi enhances Glycine max L. resilience to combined abiotic stresses: Heavy metals, high temperature and drought stress. Ind. Crops Prod. 2020, 143, 111931. [Google Scholar] [CrossRef]
- Deng, Z.; Cao, L. Fungal endophytes and their interactions with plants in phytoremediation: A review. Chemosphere 2017, 168, 1100–1106. [Google Scholar] [CrossRef] [PubMed]
- Muro-González, D.A.; Mussali-Galante, P.; Valencia-Cuevas, L.; Flores-Trujillo, K.; Tovar-Sánchez, E. Morphological, physiological, and genotoxic effects of heavy metal bioaccumulation in Prosopis laevigata reveal its potential for phytoremediation. Environ. Sci. Pollut. Res. 2020, 27, 40187–40204. [Google Scholar] [CrossRef]
- Solís-Miranda, M. Aislamiento de Bacterias de Jales Mineros y Análisis de su Potencial para la Remediación de Sitios Contaminados con Metales Pesados. Master’s Dissertation, Autonomous University of Morelos State, Cuernavaca, Mexico, 2016. [Google Scholar]
- Ondov, B.D.; Starrett, G.J.; Sappington, A.; Kostic, A.; Koren, S.; Buck, C.B.; Phillippy, A.M. Mash screen: High-throughput sequence containment estimation for genome discovery. Genome Biol. 2019, 20, 232. [Google Scholar] [CrossRef] [PubMed]
- Khanna, K.; Kapoor, D.; Sharma, P.; Bakshi, P.; Sharma, P.; Saini, P.; Ohri, P.; Mir, B.A.; Kaur, R.; Bhardwaj, R. Plant-microbe interactions under adverse environment. In Plant Ecophysiology and Adaptation under Climate Change: Mechanisms and Perspectives I; Hasanuzzaman, M., Ed.; Springer: Singapore, 2020; pp. 717–751. [Google Scholar] [CrossRef]
- Kumar, A.; Chaturvedi, A.K.; Yadav, K.; Arunkumar, K.P.; Malyan, S.K.; Raja, P.; Kumar, R.; Khan, S.A.; Yadav, K.K.; Rana, K.L.; et al. Fungal phytoremediation of heavy metal-contaminated resources: Current scenario and prospects. In Recent Advancement in White Biotechnology through Fungi, Fungal Biology; Yadav, A.N., Singh, S., Mishra, S., Gupta, A., Eds.; Springer International Publishing: Cham, Switzerland, 2019; pp. 437–461. [Google Scholar] [CrossRef]
- Kotoky, R.; Pandey, P. Plant-microbe symbiosis as an instrument for the mobilization and removal of heavy metals from contaminated soils—A realistic approach. Curr. Biotechnol. 2018, 7, 71–79. [Google Scholar] [CrossRef]
- Miransari, M. Hyperaccumulators, arbuscular mycorrhizal fungi and stress of heavy metals. Biotechnol. Adv. 2011, 29, 645–653. [Google Scholar] [CrossRef]
- Inui, T. Ryukyu awamori hakko kin chyosa houkokusyo. J. Tokyo Chem. Soc. 1901, 22, 669–688. (In Japanese) [Google Scholar]
- Inui, T. Untersuchungen über die niederen Organismen welche sich bei der Zubereitung des alkoholischen Getränkes “Awamori” betheiligen. J. Coll. Sci. Imp. Univ. Tokyo Jpn. 1901, 15, 465–476. (In German) [Google Scholar]
- Yamada, O.; Machida, M.; Hosoyama, A.; Goto, M.; Takahashi, T.; Futagami, T.; Yamagata, Y.; Takeuchi, M.; Kobayashi, T.; Koike, H.; et al. Genome sequence of Aspergillus luchuensis NBRC 4314. DNA Res. 2016, 23, 507–515. [Google Scholar] [CrossRef]
- Hassanein, N.M.; El-Gendy, M.M.; Ibrahim, H.A.E.H.; El Baky, D.H.A. Screening and evaluation of some fungal endophytes of plant potentiality as low-cost adsorbents for heavy metals uptake from aqueous solution. Egypt. J. Exp. Biol. 2012, 8, 17–23. [Google Scholar]
- Hong, S.B.; Lee, M.; Kim, D.H.; Varga, J.; Frisvad, J.C.; Perrone, G.; Gomi, K.; Yamada, O.; Machida, M.; Houbraken, J.; et al. Aspergillus luchuensis, an industrially important black aspergillus in east Asia. PLoS ONE 2013, 8, e63769. [Google Scholar] [CrossRef]
- Maeda, M.; Tokashiki, M.; Tokashiki, M.; Uechi, K.; Ito, S.; Taira, T. Characterization and induction of phenolic acid decarboxylase from Aspergillus luchuensis. J. Biosci. Bioeng. 2018, 126, 162–168. [Google Scholar] [CrossRef] [PubMed]
- Taira, J.; Toyoshima, R.; Ameku, N.; Iguchi, A.; Tamaki, Y. Vanillin production by biotransformation of phenolic compounds in fungus, Aspergillus luchuensis. AMB Express 2018, 8, 40. [Google Scholar] [CrossRef] [PubMed]
- Kadooka, C.; Nakamura, E.; Mori, K.; Okutsu, K.; Yoshizaki, Y.; Takamine, K.; Goto, M.; Tamaki, H.; Futagami, T. LaeA controls citric acid production through regulation of the citrate exporter-encoding cexA gene in Aspergillus luchuensis mut. kawachii. Appl. Environ. Microbiol. 2020, 86, e01950-19. [Google Scholar] [CrossRef] [PubMed]
- Nakamura, E.; Kadooka, C.; Okutsu, K.; Yoshizaki, Y.; Takamine, K.; Goto, M.; Tamaki, H.; Futagami, T. Citrate exporter enhances both extracellular and intracellular citric acid accumulation in the koji fungi Aspergillus luchuensis mut. kawachii and Aspergillus oryzae. J. Biosci. Bioeng. 2021, 131, 68–76. [Google Scholar] [CrossRef] [PubMed]
- Zúñiga-Silgado, D.; Rivera-Leyva, J.C.; Coleman, J.J.; Sánchez-Reyez, A.; Valencia-Díaz, S.; Serrano, M.; de-Bashan, L.E.; Folch-Mallol, J.L. Soil type affects organic acid production and phosphorus solubilization efficiency mediated by several native fungal strains from Mexico. Microorganisms 2020, 8, 1337. [Google Scholar] [CrossRef] [PubMed]
- Rodríguez, R.J.; White, J.F., Jr.; Arnold, A.E.; Redman, R.S. Fungal endophytes: Diversity and functional roles. New Phytol. 2009, 182, 314–330. [Google Scholar] [CrossRef]
- Du, A.; Cao, L.; Zhang, R.; Pan, R. Effects of a copper-resistant fungus on copper adsorption and chemical forms in soils. Water Air Soil Pollut. 2009, 201, 99–107. [Google Scholar] [CrossRef]
- Eslamian, S. (Ed.) Urban Water Reuse Handbook; CRC Press: New York, NY, USA, 2016. [Google Scholar]
- de Wet, M.M.; Brink, G.H. Fungi in the bioremediation of toxic effluents. In Fungi Bio-Prospects in Sustainable Agriculture, Environment and Nano-Technology; Sharma, V.K., Shah, M.P., Parma, S., Kumar, A., Eds.; Elsevier: London, UK, 2021; pp. 407–431. [Google Scholar] [CrossRef]
- DalCorso, G. Heavy metal toxicity in plants. In Plants and Heavy Metals; Furini, A., Ed.; Plants and Heavy Metals, SpringerBriefs in Molcular Science; Springer: New York, NY, USA, 2012; pp. 1–25. [Google Scholar] [CrossRef]
- He, L.; Su, R.; Chen, Y.; Zeng, P.; Du, L.; Cai, B.; Zhang, A.; Zhu, H. Integration of manganese accumulation, subcellular distribution, chemical forms, and physiological responses to understand manganese tolerance in Macleaya cordata. Environ. Sci. Pollut. Res. 2022, 29, 39017–39026. [Google Scholar] [CrossRef]
- Li, H. Minimap2: Pairwise alignment for nucleotide sequences. Bioinformatics 2018, 34, 3094–3100. [Google Scholar] [CrossRef]
- Katoh, K.; Standley, D.M. MAFFT Multiple Sequence Alignment Software Version 7: Improvements in performance and usability. Mol. Biol. Evol. 2013, 30, 772–780. [Google Scholar] [CrossRef]
- Capella-Gutierrez, S.; Silla-Martinez, J.M.; Gabaldon, T. trimAl: A tool for automated alignment trimming in large-scale phylogenetic analyses. Bioinformatics 2009, 25, 1972–1973. [Google Scholar] [CrossRef] [PubMed]
- Gouy, M.; Guindon, S.; Gascuel, O. SeaView Version 4: A Multiplatform graphical user interface for sequence alignment and phylogenetic tree building. Mol. Biol. Evol. 2010, 27, 221–224. [Google Scholar] [CrossRef] [PubMed]
- Tamura, K.; Nei, M. Estimation of the number of nucleotide substitutions in the control region of mitochondrial DNA in humans and chimpanzees. Mol. Biol. Evol. 1993, 10, 512–526. [Google Scholar] [CrossRef] [PubMed]
- Lefort, V.; Longueville, J.E.; Gascuel, O. SMS: Smart Model Selection in PhyML. Mol. Biol. Evol. 2017, 34, 2422–2424. [Google Scholar] [CrossRef]
- Gold, K.P.; León-Lobos, Y.; Way, M. Manual de Recolección de Semillas de Plantas Silvestres, Boletín INIA N°110; Instituto de Investigaciones Agropecuarias, Centro Regional de Investigación INTIHUASI: La Serena, Chile, 2004. [Google Scholar]
- Zar, J.H. Biostatistical Analysis, 5th ed.; Prentice Hall: Hoboken, NJ, USA, 2010. [Google Scholar]
- Yoon, J.; Cao, X.; Zhou, Q.; Ma, L.Q. Accumulation of Pb, Cu, and Zn in native plants growing on a contaminated Florida site. Sci. Total Environ. 2006, 368, 456–464. [Google Scholar] [CrossRef]
- Covarrubias, S.A.; Cabriales, P.J. Contaminación ambiental por metales pesados en México: Problemática y estrategias de fitorremediación. Rev. Int. Contam. Ambient. 2017, 33, 7–21. [Google Scholar] [CrossRef]
- Hammer, Ø.; Harper, D.A.; Ryan, P.D. PAST: Paleontological statistics software package for education and data analysis. Palaeontol. Electron. 2001, 4, 9. [Google Scholar]
- Statsoft, Inc. Statistica for Windows; Statsoft, Inc.: Tulsa, OK, USA, 2007. [Google Scholar]

| Metals (ppm) | ||||||
|---|---|---|---|---|---|---|
| Strain | Cu | Zn | Pb | |||
| 50 | 200 | 300 | 1600 | 600 | 4000 | |
| C1 | +++ | +++ | +++ | - | +++ | ++ |
| C2 | +++ | +++ | +++ | - | +++ | ++ |
| C3 | ++ | ++ | ++ | + | ++ | ++ |
| C4 | ++ | ++ | ++ | - | ++ | ++ |
| C5 | +++ | +++ | +++ | ++ | +++ | ++ |
| C6 | +++ | ++ | ++ | + | ++ | - |
| C7 | +++ | +++ | +++ | - | +++ | +++ |
| C8 | +++ | +++ | +++ | - | +++ | +++ |
| C9 | + | + | + | - | ++ | - |
| C10 | +++ | +++ | +++ | + | +++ | + |
| Accession | Description | Identity (%) | Score | Cover (%) | E Value |
|---|---|---|---|---|---|
| XR_005976915.1 | Aspergillus luchuensis IFO 4304 28S | 99.81 | 6752 | 100 | 0 |
| XR_005951996.1 | Aspergillus flavus NRRL3357 28S | 97.83 | 6342 | 100 | 0 |
| JN642222.1 | Penicillium solitum 20-01 28S | 96.22 | 6006 | 99 | 0 |
| LC573714.1 | Aspergillus luchuensis NBRC 6086 calmodulin (partial cds) | 96.79 | 1230 | 100 | 0 |
| EF661152.1 | Aspergillus tubingensis NRRL 4750 calmodulin (partial cds) | 96.73 | 1203 | 97 | 0 |
| KF900176.1 | Penicillium dimorphosporum NRRL 5207 calmodulin (partial cds) | 84.07 | 398 | 56 | 2 × 10−7 |
| LC573653.2 | Aspergillus luchuensis NBRC:4033 beta-tubulin (partial cds) | 95.81 | 1563 | 100 | 0 |
| LC573644.1 | Aspergillus foetidus NBRC:4338 beta-tubulin (partial cds) | 95.81 | 1563 | 100 | 0 |
| AY846880.1 | Penicillium paxilli CBS:360.48 beta-tubulin (complete cds) | 86.50 | 911 | 86 | 0 |
| Accession | Description | Mutational Distance (D) | Shared Hashes | Mash Screen Identity | Shared Hashes |
|---|---|---|---|---|---|
| GCA_016861625.1 | Aspergillus luchuensis | 0.0375603 | 294/1000 | 0.984152 | 715/1000 |
| GCA_003184755.1 | Aspergillus piperis | 0.0533217 | 195/1000 | 0.97022 | 530/1000 |
| GCA_003184625.1 | Aspergillus neoniger | 0.0747985 | 116/1000 | 0.95188 | 355/1000 |
| GCA_003184535.1 | Aspergillus eucalypticola | 0.0740698 | 118/1000 | 0.951367 | 351/1000 |
| Characters | |||||||
|---|---|---|---|---|---|---|---|
| Treatment (Substrate) | Dry Root Biomass | Dry Leaf Biomass | Height | Number of Leaves | Wet Root Biomass | Wet Leaf Biomass | |
| Month 1 | |||||||
| Control with fungi | 0.050 ± 0.000 a | 0.075 ± 0.011 a | 11.462 ± 0.329 a | 18.667 ± 0.615 a | 0.375 ± 0.042 a | 0.158 ± 0.008 a | |
| Control without fungi | 0.042 ± 0.014 a | 0.047 ± 0.012 ac | 9.167 ± 0.710 b | 16.000 ± 1.461 ac | 0.283 ± 0.053 a | 0.047 ± 0.012 b | |
| Tailing with fungi | 0.005 ± 0.002 b | 0.011 ± 0.002 b | 6.000 ± 0.485 c | 9.333 ± 0.955 b | 0.034 ± 0.011 b | 0.033 ± 0.005 b | |
| Tailing without fungi | 0.007 ± 0.001 b | 0.018 ± 0.002 bc | 6.700 ± 0.331 c | 12.100 ± 1.915 bc | 0.062 ± 0.009 b | 0.054 ± 0.006 b | |
| ANOVA | F3,20 = 11.169 *** | F3,20 = 12.279 *** | F3,20 = 25.502 *** | F3,20 = 9.697 *** | F3,20 = 23.379 *** | F3,20 = 48.903 *** | |
| Month 2 | |||||||
| Control with fungi | 0.199 ± 0.030 a | 0.134 ± 0.025 a | 15.617 ± 1.685 a | 28.833 ± 0.038 a | 0.859 ± 0.133 a | 0.317 ± 0.070 a | |
| Control without fungi | 0.064 ± 0.016 b | 0.033 ± 0.007 b | 8.000 ± 0.639 b | 11.167 ± 1.400 b | 0.343 ± 0.092 b | 0.065 ± 0.015 b | |
| Tailing with fungi | 0.045 ± 0.015 b | 0.024 ± 0.007 b | 8.017 ± 0.670 b | 13.833 ± 2.120 b | 0.334 ± 0.099 b | 0.060 ± 0.021 b | |
| Tailing without fungi | 0.036 ± 0.009 b | 0.025 ± 0.005 b | 7.917 ± 0.559 b | 14.500 ± 2.579 b | 0.258 ± 0.065 b | 0.059 ± 0.013 b | |
| ANOVA | F3,20 = 15.716 *** | F3,20 = 13.350 *** | F3,20 = 14.553 *** | F3,20 = 8.735 *** | F3,20 = 7.579 ** | F3,20 = 11.419 *** | |
| Month 3 | |||||||
| Control with fungi | 0.416 ± 0.059 a | 0.119 ± 0.025 a | 14.000 ± 0.899 a | 35.500 ± 3.030 a | 2.159 ± 0.272 a | 0.294 ± 0.772 a | |
| Control without fungi | 0.152 ± 0.040 b | 0.046 ± 0.013 b | 7.883 ± 0.558 b | 24.000 ± 6.648 ab | 0.837 ± 0.170 b | 0.109 ± 0.034 b | |
| Tailing with fungi | 0.094 ± 0.028 b | 0.018 ± 0.004 b | 7.367 ± 0.801 b | 12.167 ± 3.038 b | 0.414 ± 0.122 b | 0.034 ± 0.009 b | |
| Tailing without fungi | 0.092 ± 0.029 b | 0.020 ± 0.009 b | 8.083 ± 0.961 b | 9.667 ± 2.348 b | 0.266 ± 0.026 b | 0.038 ± 0.022 b | |
| ANOVA | F3,20 = 14.266 *** | F3,20 = 9.847 *** | F3,20 = 14.552 *** | F3,20 = 7.619 ** | F3,20 = 24.999 ** | F3,20 = 7.694 *** | |
| Month 4 | |||||||
| Control with fungi | 0.248 ± 0.033 a | 0.087 ± 0.016 a | 10.083 ± 1.228 a | 38.833 ± 7.507 a | 1.381 ± 0.095 a | 0.144 ± 0.043 a | |
| Control without fungi | 0.145 ± 0.030 ab | 0.040 ± 0.005 b | 8.317 ± 0.599 a | 25.167 ± 3.945 ab | 0.943 ± 0.145 ab | 0.066 ± 0.009 ab | |
| Tailing with fungi | 0.139 ± 0.031 ab | 0.024 ± 0.008 b | 9.267 ± 0.847 a | 14.000 ± 3.055 b | 0.550 ± 0.136 bc | 0.040 ± 0.016 b | |
| Tailing without fungi | 0.081 ± 0.016 b | 0.020 ± 0.004 b | 6.717 ± 0.668 a | 18.333 ± 3.148 b | 0.398 ± 0.089 c | 0.029 ± 0.006 b | |
| ANOVA | F3,20 = 6.161 ** | F3,20 = 10.138 *** | F3,20 = 2.760 n.s. | F3,20 = 5.170 ** | F3,20 = 13.713 ** | F3,20 = 4.693 * | |
| Month 5 | |||||||
| Control with fungi | 0.610 ± 0.77 a | 0.136 ± 0.021 a | 16.217 ± 2.371 a | 47.500 ± 7.065 a | 3.389 ± 0.431 a | 0.287 ± 0.047 a | |
| Control without fungi | 0.149 ± 0.023 b | 0.034 ± 0.012 b | 8.533 ± 1.102 b | 24.333 ± 6.922 b | 1.015 ± 0.192 b | 0.0625 ± 0.227 b | |
| Tailing with fungi | 0.221 ± 0.141 b | 0.019 ± 0.004 b | 7.183 ± 0.379 b | 15.000 ± 3.225 b | 0.412 ± 0.054 b | 0.031 ± 0.008 b | |
| Tailing without fungi | 0.153 ± 0.041 b | 0.026 ± 0.010 b | 8.933 ± 1.438 b | 14.000 ± 3.225 b | 0.675 ± 0.173 b | 0.041 ± 0.015 b | |
| ANOVA | F3,20 = 6.930 ** | F3,20 = 17.404 *** | F3,20 = 7.323 ** | F3,20 = 8.177 *** | F3,20 = 29.255 *** | F3,20 = 19.623 *** | |
| Month 6 | |||||||
| Control with fungi | 0.633 ± 0.105 a | 0.195 ± 0.026 a | 16.517 ± 1.377 a | 98.833 ± 14.827 a | 2.625 ± 0.369 a | 0.367 ± 0.042 a | |
| Control without fungi | 0.237 ± 0.034 b | 0.071 ± 0.010 b | 10.550 ± 0.617 b | 42.667 ± 8.838 b | 1.158 ± 0.171 b | 0.126 ± 0.025 b | |
| Tailing with fungi | 0.055 ± 0.003 b | 0.032 ± 0.013 b | 7.240 ± 0.430 b | 14.800 ± 1.077 b | 0.549 ± 0.098 b | 0.040 ± 0.006 b | |
| Tailing without fungi | 0.037 ± 0.012 b | 0.022 ± 0.009 b | 6.600 ± 0.678 b | 20.500 ± 6.840 b | 0.416 ± 0.257 b | 0.045 ± 0.019 b | |
| ANOVA | F3,20 = 24.882 *** | F3,20 = 24.328 *** | F3,20 = 28.186 *** | F3,20 = 17.012 *** | F3,20 = 16.948 *** | F3,20 = 33.850 *** | |
| Time | Lead (Pb) | Copper (Cu) | Zinc (Zn) | |||
|---|---|---|---|---|---|---|
| (Months) | With Fungi | Without Fungi | With Fungi | Without Fungi | With Fungi | Without Fungi |
| 1 | 4.2 ± 0.75 | 0.3 ± 0.02 | 0.1 ± 0.04 | 0.3 ± 0.04 | 0.0 ± 0.02 | 0.0 ± 0.00 |
| 2 | 2.6 ± 0.34 | 1.3 ± 0.44 | 0.9 ± 0.19 | 1.2 ± 0.33 | 0.3 ± 0.00 | 0.5 ± 0.06 |
| 3 | 8.1 ± 1.02 | 10.1 ± 1.98 | 4.0 ± 0.20 | 7.3 ± 0.65 | 6.2 ± 0.88 | 4.1 ± 0.81 |
| 4 | 1.2 ± 0.28 | 2.6 ± 0.35 | 1.7 ± 0.22 | 3.3 ± 0.75 | 1.4 ± 0.33 | 3.6 ± 0.89 |
| 5 | 4.0 ± 1.13 | 7.3 ± 1.18 | 8.4 ± 0.69 | 8.3 ± 1.24 | 2.6 ± 0.61 | 6.1 ± 0.40 |
| 6 | 5.3 ± 1.01 | 1.9 ± 0.42 | 16.9 ± 3.65 | 5.9 ± 0.92 | 10.0 ± 1.25 | 0.9 ± 0.27 |
| Mean | 4.2 ± 0.48 | 3.9 ± 0.70 | 5.3 ± 1.14 | 4.4 ± 0.58 | 3.4 ± 0.66 | 2.5 ± 0.43 |
| r = 0.075, | r = 0.450, | r = 0.870, | r = 0.737, | r = 0.710, | r = 0.455, | |
| Regression | r2 = 0.243, | r2 = 0.202, | r2 = 0.695, | r2 = 0.429, | r2 = 0.340, | r2 = 0.008, |
| p = 0.888 | p = 0.370 | p = 0.024 | p = 0.09 | p = 0.114 | p = 0.365 | |
Disclaimer/Publisher’s Note: The statements, opinions and data contained in all publications are solely those of the individual author(s) and contributor(s) and not of MDPI and/or the editor(s). MDPI and/or the editor(s) disclaim responsibility for any injury to people or property resulting from any ideas, methods, instructions or products referred to in the content. |
© 2023 by the authors. Licensee MDPI, Basel, Switzerland. This article is an open access article distributed under the terms and conditions of the Creative Commons Attribution (CC BY) license (https://creativecommons.org/licenses/by/4.0/).
Share and Cite
Tovar-Sánchez, E.; Concepción-Acosta, C.M.; Sánchez-Reyes, A.; Sánchez-Cruz, R.; Folch-Mallol, J.L.; Mussali-Galante, P. Aspergillus luchuensis, an Endophyte Fungus from the Metal Hyperaccumulator Plant Prosopis laevigata, Promotes Its Growth and Increases Metal Translocation. Plants 2023, 12, 1338. https://doi.org/10.3390/plants12061338
Tovar-Sánchez E, Concepción-Acosta CM, Sánchez-Reyes A, Sánchez-Cruz R, Folch-Mallol JL, Mussali-Galante P. Aspergillus luchuensis, an Endophyte Fungus from the Metal Hyperaccumulator Plant Prosopis laevigata, Promotes Its Growth and Increases Metal Translocation. Plants. 2023; 12(6):1338. https://doi.org/10.3390/plants12061338
Chicago/Turabian StyleTovar-Sánchez, Efraín, Cynthia Margarita Concepción-Acosta, Ayixon Sánchez-Reyes, Ricardo Sánchez-Cruz, Jorge Luis Folch-Mallol, and Patricia Mussali-Galante. 2023. "Aspergillus luchuensis, an Endophyte Fungus from the Metal Hyperaccumulator Plant Prosopis laevigata, Promotes Its Growth and Increases Metal Translocation" Plants 12, no. 6: 1338. https://doi.org/10.3390/plants12061338
APA StyleTovar-Sánchez, E., Concepción-Acosta, C. M., Sánchez-Reyes, A., Sánchez-Cruz, R., Folch-Mallol, J. L., & Mussali-Galante, P. (2023). Aspergillus luchuensis, an Endophyte Fungus from the Metal Hyperaccumulator Plant Prosopis laevigata, Promotes Its Growth and Increases Metal Translocation. Plants, 12(6), 1338. https://doi.org/10.3390/plants12061338

